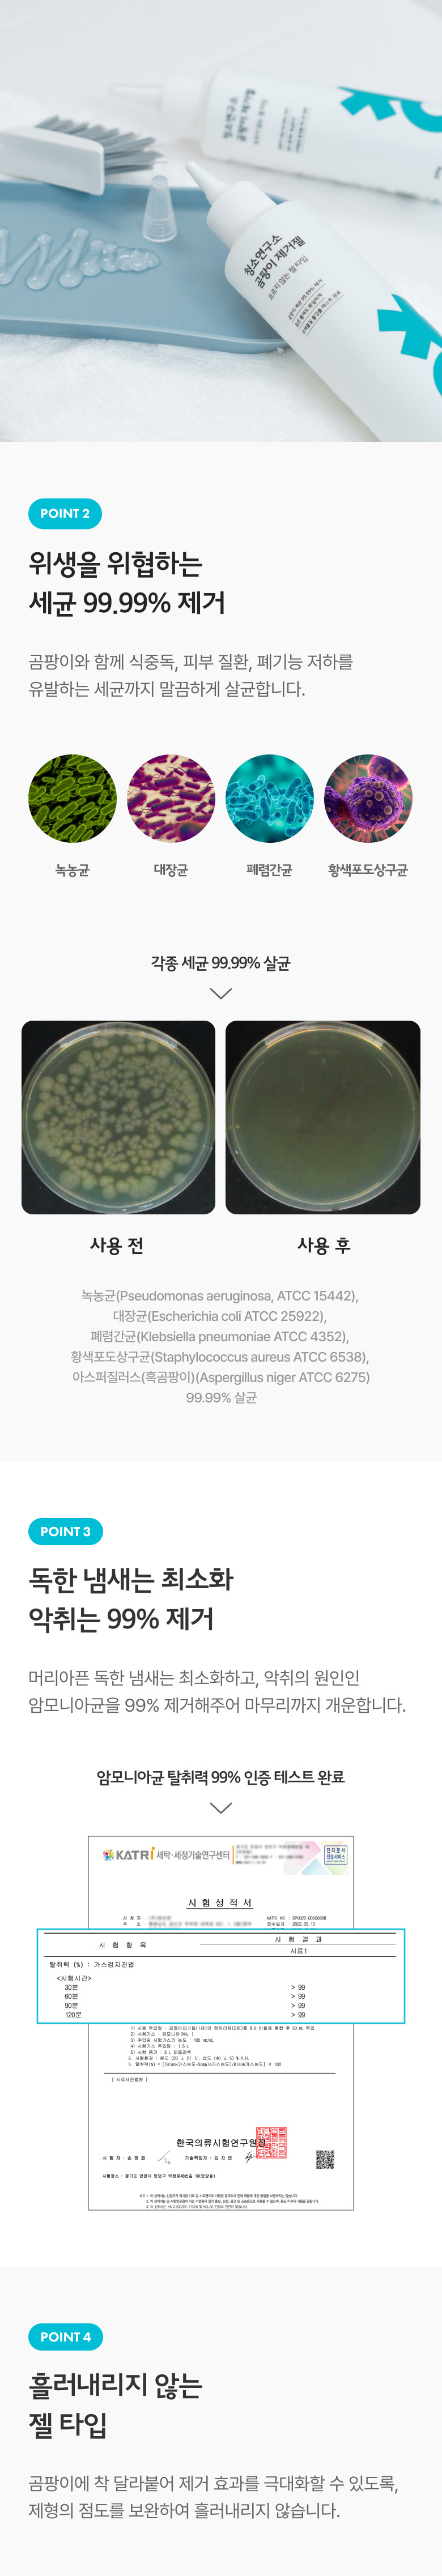

CHYEON Mold Removal Gel 200g × 4EA – Non-Drip High Viscosity Formula for Grout & Silicone, 99.999% Mold & Spore Elimination, Deep Gap Cleaner, Strong Sanitizing Action _ Made in KOREA
0 reviews
0 sold. Only 998 remain
USD $15.81
USD $30.26
-48%
Negotiable (specific conditions to required)
Brands Cleaninglab
Product Code: CHYEON_Mold Remover
Stock In Stock
Viewed 348 times
Ship from South Korea
House Brand available (OEM, ODM, OBM)
Dropshipping available
Seller information